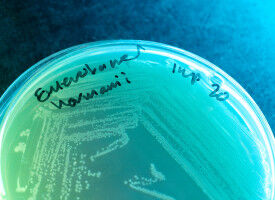
GSK and Fleming Initiative scientists unite to target AMR with advanced AI

wire
Categories
- Administration
- Agronomy & Food Science
- Architecture & Buildings
- Art & Design
- Astronomy & Space
- Campus
- Career
- Chemistry
- Civil Engineering
- Computer Science
- Earth Sciences
- Economics
- Electroengineering
- Environment
- Event
- Forensic Science
- Geography
- Health
- History & Archeology
- Innovation
- Interdisciplinary/All Categories
- Law
- Life Sciences
Last News
Results 651 - 700 of 1125.
Environment - Research Management - 19.11.2025
University of Glasgow ranks in world top 30 for Sustainability
Transport - 19.11.2025
Moving to London as an international student
Campus - 19.11.2025
Portico upgrade advance notice
Health - Life Sciences - 19.11.2025
University of Glasgow’s Prof Antonia Ho awarded Fleming Prize by the Microbiology Society
Health - Computer Science - 19.11.2025
AI tool can analyse complex cancer images rapidly - offering potential to personalise treatment
Complex digital images of tissue samples that can take an experienced pathologist up to 20 minutes to annotate could be analysed in just one minute using a new AI tool developed by researchers at the University of Cambridge.
Health - 19.11.2025

An AI tool that can analyse abnormalities in the shape and form of blood cells, and with greater accuracy and reliability than human experts, could change the way conditions such as leukaemia are diagnosed. Researchers have created a system called CytoDiffusion that uses generative AI - the same type of technology behind image generators such as DALL-E - to study the shape and structure of blood cells.
Career - 19.11.2025
Spotlight on... Dr Mathelinda Nabugodi
Event - Social Sciences - 19.11.2025
Disability History Month 2025 at UCL
Campus - Career - 19.11.2025

Health - Veterinary - 18.11.2025
2075 percent rise in surgeries for French Bulldogs
New research from the Royal Veterinary College (RVC) has revealed a 2075% increase in soft-tissue surgical referrals over the past 10 years for French Bulldogs at the RVC's Queen Mother Hospital for Animals (QMHA ) in London.
Health - Social Sciences - 18.11.2025

Innovation - Career - 18.11.2025
Expert Comment: How concerned should we be about ’carebots’
Environment - Research Management - 18.11.2025

Event - Innovation - 18.11.2025

Environment - Innovation - 18.11.2025
UCL ranks 1st in the UK and 3rd globally in QS Sustainability Rankings
Event - 18.11.2025
UCL200 Summer Festival by Students’ Union UCL
Health - Pharmacology - 18.11.2025
Oxford and GSK launch Experimental Medicine Collaboration
History & Archeology - 18.11.2025
Unearthing the City of Seven Ravines
The remains of an extensive Bronze Age settlement on the Kazakh Steppe that was likely once a major regional hub for large-scale bronze production more than 3,500 years ago, have been revealed by an international team of archaeologists co-led by researchers from UCL.
Pharmacology - Health - 18.11.2025
£45m in GSK funding has been allocated to new research programmes combining expertise and using cutting edge AI technology to accelerate AMR research.
Health - Life Sciences - 18.11.2025

Environment - 18.11.2025

Politics - 18.11.2025
Opinion: Trump’s Latin America strategy risks creating a military quagmire
Psychology - Health - 18.11.2025
Social media use drives distrust among Gen Z teenage girls
Social media use in adolescence is linked to delayed bedtimes, negative self-image and, especially among teenage girls, greater distrust, a new UCL study shows. In turn, these changes are associated with more symptoms of depression and anxiety, risk of self-harm, and suicidal behaviours several years later.
Campus - Forensic Science - 18.11.2025
Responding to antisemitic incidents at UCL
Environment - Research Management - 18.11.2025
Leeds rises in QS Sustainability Rankings
Pedagogy - Campus - 17.11.2025

Life Sciences - Health - 17.11.2025
Scientists pinpoint single gene responsible for initiating winter behaviour of mammals
As the days continue to get shorter scientists have made a significant step in understanding exactly what makes mammals exhibit seasonal behaviours like hibernation and migration. The study - published in the journal eLife and led by the University of Glasgow - pinpoints a single gene, the Dio3 gene, present across all mammals, as the biological mechanism behind seasonal behaviours.
Environment - Economics - 17.11.2025
UCL Accommodation launches urbanest Canary Wharf, world’s largest Passivhaus student accommodation
Environment - Health - 17.11.2025
Reducing the risks of wildlife corridors
Efforts to join up isolated plant and animal habitats across the world should also protect against unintentionally harming them, new research shows. The paper, led by the Universities of Leeds and Oxford and published in Nature Reviews Biodiversity , states that work to connect fragmented wildlife habitats is essential - but it may also pose ecological risks including the unintentional spread of wildlife diseases and invasive species.
Health - 15.11.2025

I'd gone to the doctor countless times with back pain but I found it hard to explain how bad it was.
Health - Innovation - 14.11.2025
Smart textiles bra to help detect cancer for women with intellectual disabilities
Women with intellectual disabilities could receive added monitoring for breast cancer with the development of a smart textiles bra by researchers at the University of Glasgow and Nottingham Trent University (NTU).
Life Sciences - Health - 14.11.2025
Pioneering UCL Huntington’s researcher wins major neuroscience award
Social Sciences - 14.11.2025
Could you be a Student Storyteller?
Social Sciences - Campus - 14.11.2025
Community cinema welcomes Sir Ian McKellen
Social Sciences - 13.11.2025
Innovating inclusion: Creative methods for non-speaking communities
Art & Design - Career - 13.11.2025
The arts can transform young people’s wellbeing and deliver big economic returns
Psychology - Social Sciences - 13.11.2025
Transgender Awareness Week and Transgender Day of Remembrance 2025
Art & Design - Career - 13.11.2025
Grassroots groups receive more than £55,000 from the second round of the University of Glasgow’s GRID Civic Grant Fund
Economics - Innovation - 13.11.2025

Campus - 13.11.2025
Your voice, your UCL: how your feedback is shaping a better campus experience
Career - 13.11.2025
Opinion: Teacher recruitment and retention are separate issues-they need tackling in different ways
Campus - 13.11.2025
UCL statement in response to antisemitic event
Health - Life Sciences - 12.11.2025
Over ¤10m EU funding boosts UCL cancer and neuroscience research
Environment - Economics - 12.11.2025
Why China’s central bank is quietly leading the world on climate action
Economics - Innovation - 12.11.2025
Scottish students startup summit aims to ignite the next generation of games and tech entrepreneurs
Politics - 12.11.2025
Employment alone won’t turn the tide on child poverty, new analysis warns
Paleontology - Life Sciences - 12.11.2025
New species of fungus in 407-million-year-old plant fossil from Scotland
An ancient plant-fungus partnership has been revealed using advanced microscopy imaging, providing evidence of the mutually beneficial relationship that enabled plants to adapt to life on land. Our new technique is opening an exciting new window on life's earliest chapters. Raymond Wightman Researchers from the University of Cambridge and the Natural History Museum, London have identified a new species of ancient symbiotic fungus preserved within a 407-million-year-old plant fossil from Scotland.
Law - Environment - 12.11.2025
Expert Comment: how can we turn court rulings into real climate action?
Basak Çali , Head of Research and Professor of International Law at the Bonavero Institute of Human Rights , Faculty of Law , asks whether judicial climate rulings can make a real difference to the climate crisis.
Innovation - 12.11.2025
Timetabling Transformation Programme - Future of Timetabling at UCL: All-Staff - 18 November 2025
Health - 12.11.2025
Harm reduction at UCL: Sharing support and resources with students
Campus - GLASGOW - Today
Evidence from five decades of graduates confirms Humanities skills power careers and lifelong impact
Evidence from five decades of graduates confirms Humanities skills power careers and lifelong impact
Health - Mar 13
Oxford and Serum Institute of India sign IP license agreement to advance NipahB vaccine candidate
Oxford and Serum Institute of India sign IP license agreement to advance NipahB vaccine candidate
Career - Mar 13
Faye Holland joins pioneering Cambridge x Manchester collaboration as Partnership Director
Faye Holland joins pioneering Cambridge x Manchester collaboration as Partnership Director

Economics - Mar 13
£9.6M SATURN-2 programme launched to deliver the UK's next generation of nuclear experts
£9.6M SATURN-2 programme launched to deliver the UK's next generation of nuclear experts

